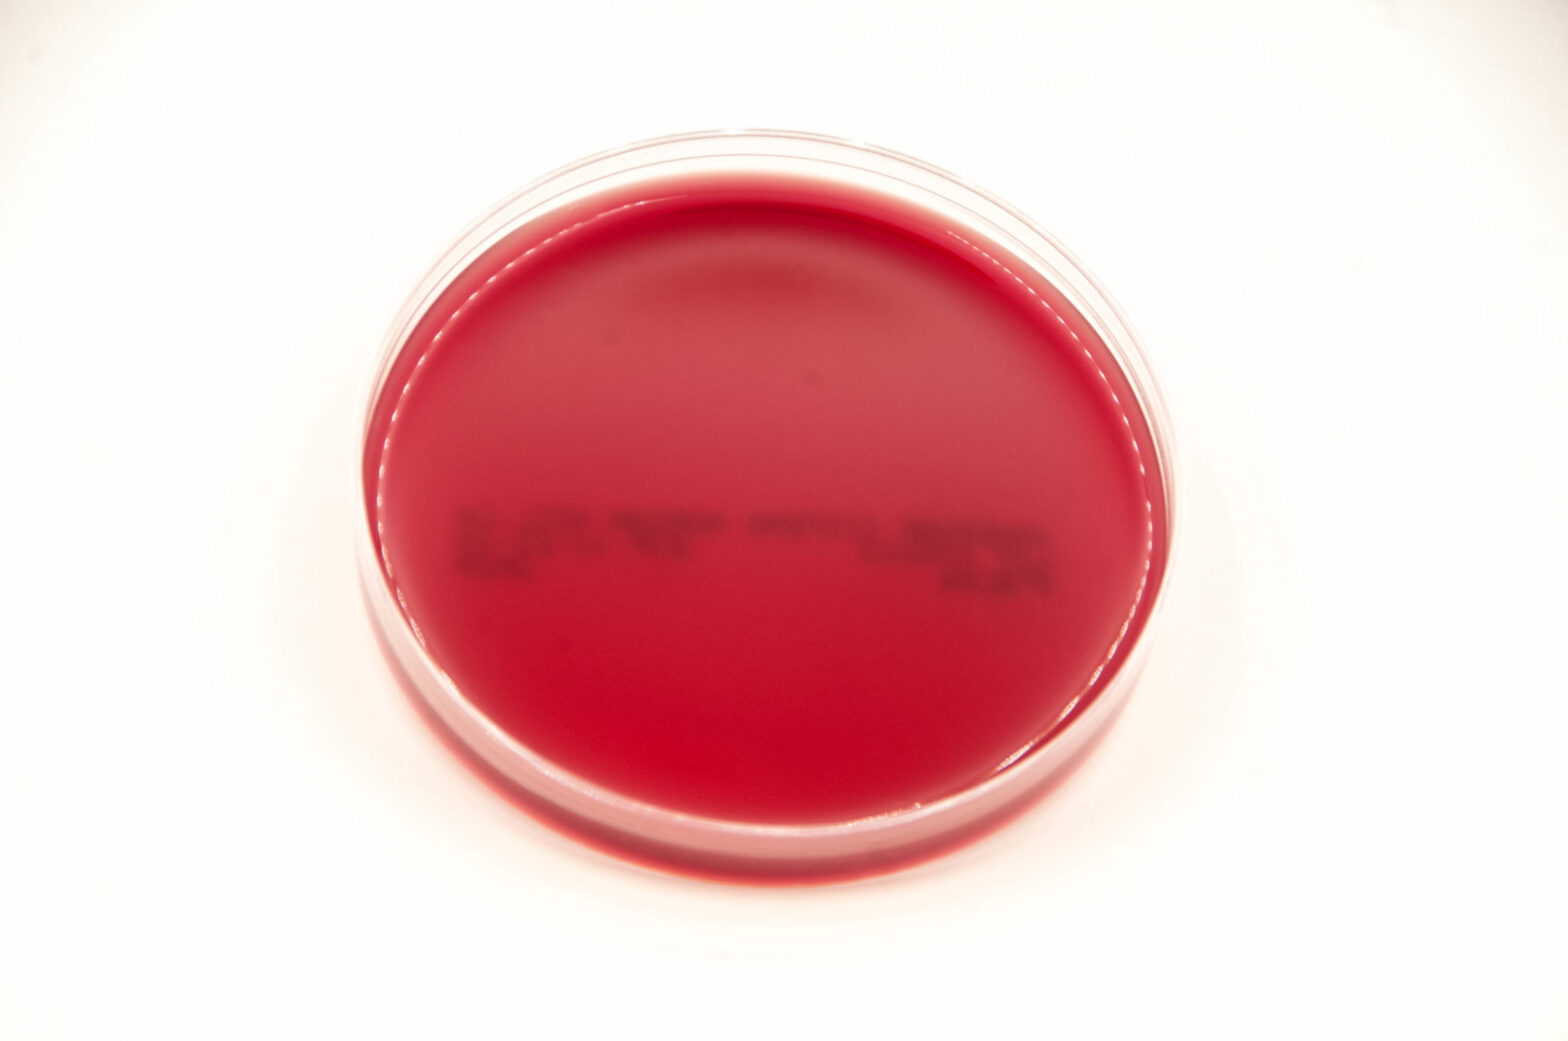
Phenylethyl Market

Phenylethyl is a chemical compound derived from ethylbenzene by removing one hydrogen atom from the side chain. Various elements such as acetaldehyde, alcohol, formate, acetate, propionate, methyl ether, phenyl acetate, acetaldehyde dimethyl acetyl, methacrylate, and isobutyrate are added in replacement of one hydrogen to the Phenylethyl compound.
The global Phenylethyl market is expected to have substantially high growth rate, attributed to growing pharmaceutical industry across the globe. North America accounts for significantly high revenue share in global Phenylethyl market, attributed to robust marketing and research in the region.
Global Phenylethyl Market Dynamics
The growth of global Phenylethyl market is driven by growing pharmaceutical industry and innovation. The macroeconomic factor responsible for the growth of global Phenylethyl market is rising disposable income, the rapid rate of urbanization, and changing lifestyle of consumers. The key factor restraining the global Phenylethyl market is the harmful effect of Phenylethyl on the cardiovascular system.
The company providing the Phenylethyl have significantly high opportunity in regions such as North America, Europe, and Asia-Pacific, owing to the significant demand for Phenylethyl with rising demand for pharmaceuticals in the regions. The Phenylethyl market also experiencing significant opportunity in Latin America and the Middle East and Africa region as these are the emerging market, attributed to rising disposable income of consumers in these region.
Request for Sample @ https://www.futuremarketinsights.com/reports/sample/rep-gb-2443
Global Phenylethyl Market Segmentation
Basically, global Phenylethyl market is segmented on the basis of product type, application, and region. On the basis of product type global Phenylethyl market is sub-segmented as phenyl ethyl acetaldehyde, phenyl ethyl alcohol, phenyl ethyl formate, phenyl ethyl acetate, phenyl ethyl propionate, phenyl ethyl methyl ether, phenyl ethyl phenyl acetate, phenyl acetaldehyde dimethyl acetyl, phenyl ethyl methacrylate, and phenyl ethyl isobutyrate.
Among the product type segment, phenyl ethyl alcohol contributes for the significant revenue share over the forecast period in global Phenylethyl market, owing to increasing demand for phenyl ethyl alcohol in the pharmaceutical industry. On the basis of end-use, the global Phenylethyl market is sub-segmented as pharmaceuticals, research institutes, and others, wherein pharmaceuticals segment contribute comparatively high revenue share.
Global Phenylethyl Market Regional Outlook
Based on the geographies, global Phenylethyl market is fragmented into seven key regions — North America, Latin America, Western Europe, Eastern Europe, Asia-Pacific except Japan, Japan, and the Middle East & Africa. Among the aforementioned regions, North America accounts for a significant share of global Phenylethyl market, owing to relatively high-value share of the region in the global pharmaceutical industry. Western Europe is followed by North America region in global Phenylethyl market.
The Asia-Pacific except Japan region accounts for significantly high volume share in global Phenylethyl market, owing to the substantial growth in the pharmaceutical industry in the region. Eastern Europe and Japan also accounts for significant value share in global Phenylethyl market.
The developing economy such as Middle East Africa and Latin America have a moderate opportunity in global Phenylethyl market, owing to the moderate growth rate in the pharmaceutical industry and growing population. Overall, the outlook for global Phenylethyl market will have a positive growth over the forecast period, owing to the increasing demand for the pharmaceuticals as an anti-counterfeiting measure.
Request for Table of Contents @ https://www.futuremarketinsights.com/toc/rep-gb-2443
Global Phenylethyl Market Player
Few players in global Phenylethyl market include Kdac Chem Pvt. Ltd., NOVORATE BIOTECH CO., LTD, Becton, Dickinson and Company, Penta Manufacturing Company, Ungerer & Company, and HARMONY ORGANICS PVT LTD.
The Report covers exhaustive analysis on
- Phenylethyl Market Segments
- Phenylethyl Market Dynamics
- Historical Actual Market Size, 2013-2015 for Phenylethyl Market
- Phenylethyl Market Size & Forecast 2016 to 2026
- Value Chain
- Phenylethyl Market Current Trends/Issues/Challenges
- Competition and Companies involved in Phenylethyl Market
- Phenylethyl Market Drivers and Restraints
The report is a compilation of first-hand information, qualitative and quantitative assessment by industry analysts, inputs from industry experts and industry participants across the value chain.
The report provides in-depth analysis of parent market trends, macro-economic indicators and governing factors along with market attractiveness as per segments. The report also maps the qualitative impact of various market factors on market segments and geographies.
Phenylethyl Market
Based on product type, the global Phenylethyl market is segmented intoPhenyl Ethyl Acetaldehyde
- Phenyl Ethyl Alcohol
- Phenyl Ethyl Formate
- Phenyl Ethyl Acetate
- Phenyl Ethyl Propionate
- Phenyl Ethyl Methyl Ether
- Phenyl Ethyl Phenyl Acetate
- Phenyl Acetaldehyde Dimethyl Acetyl
- Phenyl Ethyl Methacrylate
- Phenyl Ethyl Isobutyrate
Based on application, the global Phenylethyl market is segmented into:
- Pharmaceuticals
- Research Institutes
- Others
About FMI
Future Market Insights (ESOMAR certified market research organization and a member of Greater New York Chamber of Commerce) provides in-depth insights into governing factors elevating the demand in the market. It discloses opportunities that will favor the market growth in various segments on the basis of Source, Application, Sales Channel and End Use over the next 10-years.
Contact Us:
Future Market Insights Inc.
Christiana Corporate, 200 Continental Drive,
Suite 401, Newark, Delaware – 19713, USA
T: +1-845-579-5705
For Sales Enquiries: sales@futuremarketinsights.com
LinkedIn| Twitter| Blogs